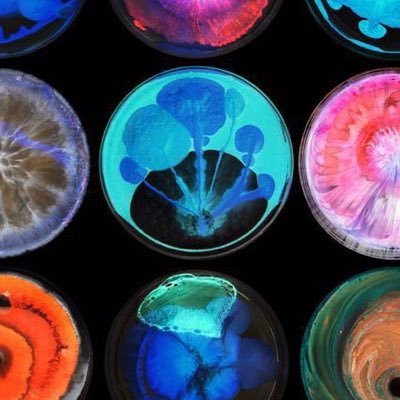
14sigarette_'s profile picture.

#sigarette search results
La più grande fabbrica clandestina di #sigarette, nascosta in un #bunker in provincia di #Frosinone. Era in grado di produrne quasi 3 miliardi l'anno
Quanto gode il #GovernoMeloni a imporre divieti, infliggere umiliazioni e inviare spedizioni punitive! L’ultimo se l’è inventato il ministro della salute, che ora propone lo stop totale al fumo all’aperto anche per le sigarette elettroniche Così Giuseppe La Micela #sigarette

La giornata precongressuale di #AIOM25 si aprirà con il convegno “5 euro in più per ogni pacchetto di #sigarette”, dedicato alla campagna di AIOM e Fondazione AIOM contro il #tabagismo. Sfoglia le immagini per il programma completo. @WalceOnlus2006 @SilvanoGallus


🚭In uno studio indipendente pubblicato su @MA_Healthcare, @MosconeF ha per la prima volta quantificato il risparmio per il sistema sanitario di una transizione verso alternative alle #sigarette tradizionali: bit.ly/FocusRicerca_M… #10agosto #ricerca

🚬Negli ultimi anni è aumentato il numero di fumatori che fanno uso di dispositivi elettronici, sia esclusivo, sia combinato alle #sigarette tradizionali. Spesso le sigarette elettroniche sono percepite come un’alternativa innocua rispetto alle classiche sigarette, ma in realtà…

In Italia, il 76,7% del prezzo di un pacchetto di sigarette è costituito da tasse. Con un aumento di 5€, si arriverebbe all’88,5%! 💸 Cosa ne pensate? #Economia #Sigarette #Tasse #Italia

Tassa su imprese. Tassa su gasolio. Tassa demmerda su #sigarette Roba che manco a Cuba. Invece di Tagliare province, enti demmerda, Tar e altro del mega carrozzone improduttivo e inutil dannoso, #Meloni demmerda fa lo stesso di Monti, Draghi, Letta: solo Tasse. VAFFANCULO.



La giornata precongressuale di #AIOM25 si apre al @SenatoStampa con il convegno di presentazione della legge di iniziativa popolare contro il #fumo "5 euro in più per ogni pacchetto di #sigarette", insieme alla Vicepresidente del #Senato @MariaDomenicaC4.

🔸 Per saperne di più, leggi l'articolo: ilsole24ore.com/art/sigarette-… #sigarette #fumo #prezzo #salute

Tassa da 5 euro sui pacchetti di sigarette, arriva la proposta di legge shock #fumo #sigarette #tassa #6novembre tgcom24.mediaset.it/cronaca/tassa-…
🚬@AIOMtweet propone un aumento di 5 euro sul costo del pacchetto di #sigarette e degli altri prodotti a fumo e inalazione di nicotina. Il presidente nazionale @fperrone62 ci ha spiegato qual è la finalità di questa iniziativa. Ascolta la puntata: tinyurl.com/3y8f7fue
પોલીસ વાનમાં જ આરોપીએ સિગારેટ ફૂંકી, સોશિયલ મીડિયા પર વીડિયો વાયરલ #Uttarpradesh #Uttarpradeshpolice #sigarette #Video
L’aumento consistente del prezzo delle #sigarette può davvero fare la differenza nella lotta al #fumo. Francesco Perrone, Presidente Nazionale #AIOM, ne ha parlato al Festival #Salute2025 di #Repubblica. Guarda l’intervista: repubblica.it/salute/dossier…

Insieme alla tassa, nel 2026 sarà introdotto un "bollino" per #sigaretteelettroniche e #liquidi, come già accade in Italia. E intanto il prezzo delle #sigarette supera i 20 euro a #pacchetto sigmagazine.it/2025/11/regno-… #vaping #ecig



Etichette del #vino come quelle delle #sigarette: l'Italia dice "no" perché "questo" non è uguale a "questo"⬇️ #vino #wine #etichette

#Taiwan #sigarette #Serracchiani #Piantedosi #Trump #Belve #Tachipirina #Cutro I MINISTRI SONO A CUTRO E UN ALTRO CADAVERE DI BIMBA ARRIVA DAL MARE SOTTOLINEANDO LE LORO COLPE CHE IL CIRCO MEDIATICO NON CANCELLA LE RESPONSABILITA'.MELONI E SALVINI HANNO SEMPRE DETTO AFFONDIAMOLI!

#DRAGHI NON VI ANDAVA BENE, RAPPRESENTAVA L'ESTABLISHMENT EUROPEO, ECCOVI QUALCOSA DI NUOVO UN #GOVERNODIPAGLIACCI CHE AUMENTA #SIGARETTE E #BENZINA 😃😃😃 MI RACCOMANDO CONTINUATE A VOTARE QUESTI #CIALTRONI ! #ilPeggior_GOVERNO_diSempre

#sigarette Questi pagliacci sono gli stessi che si lamentavano del GREEN PASS! Anche il popolo dei fumatori preso per il cu** dal #GovernoDegliOrrori


Tassa su imprese. Tassa su gasolio. Tassa demmerda su #sigarette Roba che manco a Cuba. Invece di Tagliare province, enti demmerda, Tar e altro del mega carrozzone improduttivo e inutil dannoso, #Meloni demmerda fa lo stesso di Monti, Draghi, Letta: solo Tasse. VAFFANCULO.



🔸 Per saperne di più, leggi l'articolo: ilsole24ore.com/art/sigarette-… #sigarette #fumo #prezzo #salute

In Italia, il 76,7% del prezzo di un pacchetto di sigarette è costituito da tasse. Con un aumento di 5€, si arriverebbe all’88,5%! 💸 Cosa ne pensate? #Economia #Sigarette #Tasse #Italia

🚭In uno studio indipendente pubblicato su @MA_Healthcare, @MosconeF ha per la prima volta quantificato il risparmio per il sistema sanitario di una transizione verso alternative alle #sigarette tradizionali: bit.ly/FocusRicerca_M… #10agosto #ricerca

La giornata precongressuale di #AIOM25 si aprirà con il convegno “5 euro in più per ogni pacchetto di #sigarette”, dedicato alla campagna di AIOM e Fondazione AIOM contro il #tabagismo. Sfoglia le immagini per il programma completo.


Stretta su #fumo e #sigarette, Vittorio #Feltri al ministro #Schillaci: "Prima preoccupatevi delle droghe" liberoquotidiano.it/news/piulibero…

Something went wrong.
Something went wrong.
United States Trends
- 1. Good Thursday 27.8K posts
- 2. Merry Christmas 65.8K posts
- 3. Happy Friday Eve N/A
- 4. #thursdayvibes 1,699 posts
- 5. #thursdaymotivation 2,210 posts
- 6. #DMDCHARITY2025 1.82M posts
- 7. DataHaven 11.1K posts
- 8. Hilux 7,638 posts
- 9. Toyota 27.1K posts
- 10. Halle Berry 3,917 posts
- 11. Omar 180K posts
- 12. Earl Campbell 2,280 posts
- 13. #PutThatInYourPipe N/A
- 14. Steve Cropper 8,336 posts
- 15. Metroid Prime 4 16.5K posts
- 16. #ALLOCATION 713K posts
- 17. The BIGGЕST 1.03M posts
- 18. CAFE 159K posts
- 19. Jim Jordan 23.7K posts
- 20. Milo 12.9K posts